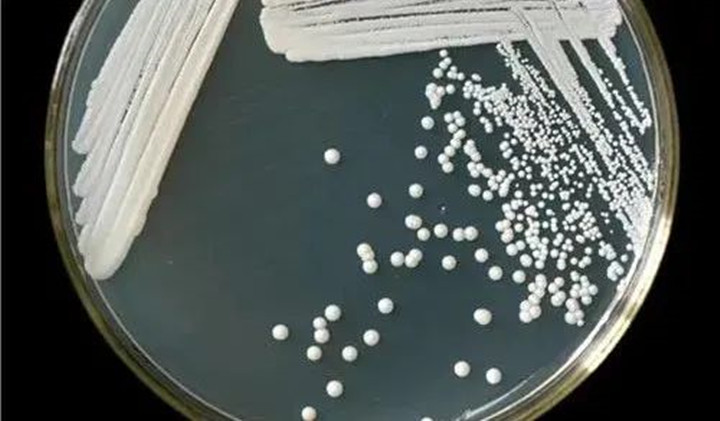
改造的高产酯酿酒酵母

白酒技术创新实践,从研究到应用(上)
2022-09-09
天津科技大学肖冬光教授长期研究食品发酵与酿造,在用现代生物技术改造传统酿造工艺的研究方面有精深研究,具国际先进水平。
在历届的酿酒微生物应用技术论坛暨论文大赛上,肖教授分享了系列研究成果。其中,对酯类物质的研究是一大亮点。

研究白酒发酵过程中酯类物质形成机理:酸酯含量高是中国白酒区别于外国蒸馏酒的主要特征。在白酒发酵过程中,酯类物质的形成非常复杂:乙酸酯主要由酵母菌在发酵期间代谢生成;己酸乙酯、丁酸乙酯主要由大曲中的酯化酶通过醇酸催化酯化合成;乳酸乙酯主要由化学反应合成。

肖冬光教授团队全面解析了白酒发酵过程中酯类物质形成特征与机理,酸度如何影响大曲酯化酶活力等,在论坛上提出的高产酯酿酒酵母菌种改造、高级醇方面的研究成果也成了现场的吸睛点。
关于高产酯酿酒酵母
酿酒酵母是白酒生产中最主要的产酒微生物,一般酿酒酵母的产酯能力有限。在白酒酿造过程中,负责产酯主要是一些非酿酒酵母,统称生香酵母。生香酵母参与酒精发酵,所产风味物质主要是乙酸乙酯,需在有氧环境下生长代谢,发酵中、后期,由于缺氧大多死亡;而酿酒酵母耐酒又耐酸,适宜在厌氧环境下生长代谢;随着发酵进程,酒醅中酿酒酵母的比例会渐增。
从生产角度考虑,直接添加生香酵母对酯类物质的提高不明显,另外不同酵母菌种之间的拮抗作用也使得应用效果可能出现不稳定的现象。肖冬光教授团队经代谢改造的高产酯酿酒酵母,不但保持了高产酒特性,同时也可以生成较高的乙酸酯,适合于各种使用方法。

高级醇代谢关联影响及调控
高级醇是酿酒酵母氨基酸代谢的副产物,对酒味形成及保持酒体的风味特征发挥重要作用。那发酵体系中α-氨基氮浓度对酿酒酵母代谢高级醇有何影响呢?


白酒技术创新实践,从研究到应用(上)
2022-09-09
天津科技大学肖冬光教授长期研究食品发酵与酿造,在用现代生物技术改造传统酿造工艺的研究方面有精深研究,具国际先进水平。
在历届的酿酒微生物应用技术论坛暨论文大赛上,肖教授分享了系列研究成果。其中,对酯类物质的研究是一大亮点。

研究白酒发酵过程中酯类物质形成机理:酸酯含量高是中国白酒区别于外国蒸馏酒的主要特征。在白酒发酵过程中,酯类物质的形成非常复杂:乙酸酯主要由酵母菌在发酵期间代谢生成;己酸乙酯、丁酸乙酯主要由大曲中的酯化酶通过醇酸催化酯化合成;乳酸乙酯主要由化学反应合成。

肖冬光教授团队全面解析了白酒发酵过程中酯类物质形成特征与机理,酸度如何影响大曲酯化酶活力等,在论坛上提出的高产酯酿酒酵母菌种改造、高级醇方面的研究成果也成了现场的吸睛点。
关于高产酯酿酒酵母
酿酒酵母是白酒生产中最主要的产酒微生物,一般酿酒酵母的产酯能力有限。在白酒酿造过程中,负责产酯主要是一些非酿酒酵母,统称生香酵母。生香酵母参与酒精发酵,所产风味物质主要是乙酸乙酯,需在有氧环境下生长代谢,发酵中、后期,由于缺氧大多死亡;而酿酒酵母耐酒又耐酸,适宜在厌氧环境下生长代谢;随着发酵进程,酒醅中酿酒酵母的比例会渐增。
从生产角度考虑,直接添加生香酵母对酯类物质的提高不明显,另外不同酵母菌种之间的拮抗作用也使得应用效果可能出现不稳定的现象。肖冬光教授团队经代谢改造的高产酯酿酒酵母,不但保持了高产酒特性,同时也可以生成较高的乙酸酯,适合于各种使用方法。
高级醇代谢关联影响及调控
高级醇是酿酒酵母氨基酸代谢的副产物,对酒味形成及保持酒体的风味特征发挥重要作用。那发酵体系中α-氨基氮浓度对酿酒酵母代谢高级醇有何影响呢?


